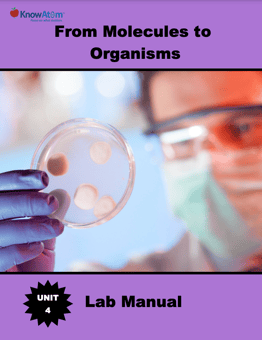
image1-Oct-09-2023-08-23-14-1835-AM

Science Lesson: Comparing Cells
All living things are made up of cells, which are the building blocks of life. In this lesson, students explore how scientists use the fossil record to track the increasing diversity and complexity of organisms on Earth by comparing ancient fossilized cells with modern organisms. Students investigate this phenomenon by comparing the complexity of modern-day prokaryotic cells with eukaryotic cells.
Science Big Ideas
- Scientists study the fossil record, which includes all of the fossils that have ever been found, to learn about the first life on Earth and how life has become increasingly complex.
- All living things share certain things in common, which makes them different from nonliving things.
- All cells can be categorized as prokaryote (pronounced proh-kar-ee- ote) or eukaryote (pronounced yoo-KAR-ee-ote). The earliest life forms on Earth were a kind of cell called prokaryote.
- Billions of years after the first prokaryotes developed, a new kind of cell called a eukaryote appeared.
- The cell is a system made up of the smaller, interacting organelles, and each organelle has a specific function that contributes to the health of the cell.
- The similarities between prokaryotes and eukaryotes provides scientists with enough evidence to conclude that all modern-day cells, both prokaryotes and eukaryotes, likely came from the same ancestor billions of years ago.
- Plant and animal cells share most of the same organelles because they are both eukaryotes, but there are some differences. The cells of plants and animals have different structures to perform the specific functions of each organism.

Discover Complete Hands-on Screens-off Core Science Curriculum for K-8 Classrooms
Prepared hands-on materials, full year grade-specific curriculum, and personalized live professional development designed to support mastery of current state science standards.
Science Essential Questions
- How do cells allow organisms to capture energy, grow, and pass along genetic information?
- How can scientists determine the numeric age of a fossil or rock?
- Why is there some debate about when the first eukaryotic cell developed?
- How are prokaryotes and eukaryotes similar? How are they different?
- Why is it important for the cell to produce and use proteins?
- How does the cell know to build the right kinds of proteins?
- Why do eukaryotic cells have mitochondria?
- What is the function of the chloroplasts in plant cells?
- Why don’t all plant cells have chloroplasts?
- How do plant cells function differently from animal cells?
Common Science Misconceptions
Misconception: Cells are completely separate from atoms and molecules.
Fact: Cells are matter, which means they are made up of atoms and molecules. For example, proteins are part of every cell.
Misconception: Animal cells do not carry out essential life functions, such as obtaining energy and eliminating waste, themselves.
Fact: Cells are living things, so every cell carries out essential life functions. For example, every cell needs energy and the proper nutrients to survive, and it needs to eliminate waste. Every cell also builds all the proteins it needs to function.
Science Vocabulary
Animal : a kingdom of eukaryotic organisms that eat other organisms for energy, breathe oxygen, and undergo growth and reproduction
Cell : the smallest unit of life; makes up single-celled and multi-celled organisms; surrounded by a cell membrane and filled with cytoplasm
Cell membrane : a protective membrane that surrounds a cell and selects which molecules can enter and exit the cell
Chloroplasts : organelles in plant cells that use sunlight, carbon dioxide, and water to produce oxygen molecules and food for the plant through a process called photosynthesis; contain chlorophyll, which gives plants their green color
Cytoplasm : the jelly-like liquid that fills a cell and holds its structures
Eukaryotes : single or multi-celled organisms that have a nucleus and membrane-bound organelles
Organelle : a small part that carries out specific functions in a cell
Organism : a complete living thing; has the ability to carry out all functions for life
Mitochondria : organelles that are the power centers of the cell; combine sugar from food with oxygen from respiration to produce molecules the cell uses for energy (ATP)
Nucleus : a membrane-bound organelle that holds an organism’s genetic material (DNA)
Nutrients : chemicals that organisms need for the growth and maintenance of cells
Plant : a kingdom of eukaryotic organisms; includes organisms that contain chloroplasts in their cells to capture energy from sunlight for growth and development
Prokaryotes : single-celled organisms that do not have a nucleus or membrane-bound organelles
Protein : a large, complex molecule that plays many important roles in all organisms
Lexile(R) Certified Non-Fiction Science Reading (Excerpt)
Earth’s Earliest Life Forms
On one of the oldest known beaches in the world, scientists have discovered what they believe are some of the world’s oldest fossils. Fossils are the remains of ancient animals and plants, the traces or impressions of living things from past geologic ages, or the traces of their activities.
A geologist named Martin Brasier was part of a team that discovered the fossils within grains of sand on the ancient beach. Scientists had already determined that the beach was about 3.4 billion years old. Scientists use a method called radiometric dating to determine the numeric age of a rock or fossil. This method is very complicated, but essentially it measures the radioactive decay of different elements within a rock or fossil to measure its age. Brasier was examining the rocks when he noticed structures in the rock that looked like cells. Cells are the smallest units of life, and all living things are made up of cells, either one cell or many cells.
Scientists have found fossilized cells dating back between 3.5 and 3.8 billion years, giving them an estimate about when life first formed on Earth. These first organisms were small single-celled organisms. An organism is a complete living thing that has the ability to carry out all functions for life. In a single-celled organism, its one cell carries out all essential life functions. In multi-celled organisms, different cells work together to keep the organism functioning.
These first fossils were unlike non-living things because they captured and used energy that came from an external source, and they grew by adding molecules obtained through nutrients to their structure. They also passed along genetic information from generation to generation. We’ll explore all of these ideas later.
Clues of Life
There were several clues that Brasier and his team looked for to determine that the fossils were indeed evidence of past life and not just unusual parts of the rock. Scientists use what they know about life today to make assumptions about past life on Earth.
One clue that Brasier and his team found was that the cells appeared to be surrounded by a membrane. The cell membrane is a protective membrane that surrounds a cell and selects what molecules can enter and exit the cell. The cell membrane is like a skin that has many pores. Scientists know that all cells today are surrounded by a cell membrane, and so signs of a cell membrane are evidence for past life.
Another clue was that the fossilized cells were found grouped together. This supported the idea that what they found were once living because modern-day bacteria cluster together near sources of food.
And scientists found different versions of sulfur in and around the fossilized cells. This was evidence for the scientists that the bacteria were taking in sulfur from the environment and processing it in their bodies to get energy—a key indicator of life. All cells must receive a constant supply of energy from nutrients—the chemicals that organisms need for energy and for building and maintaining the parts of a cell. We get nutrients from food and drinks.

Hands-on Science Activity
For the hands-on activity of this lesson, students create wet mount slides and observe prepared slides to compare and contrast the complexity of prokaryote and eukaryote cells. This investigation serves as an opportunity to discover evidence to describe how all organisms that have ever existed on Earth share certain characteristics, but there are also differences in the complexities of different organisms.
Science Assessments
KnowAtom incorporates formative and summative assessments designed to make students thinking visible for deeper student-centered learning.
- Vocabulary Check
- Lab Checkpoints
- Concept Check Assessment
- Concept Map Assessment
- And More...


See How KnowAtom Aligns to NGSS Science Standards
Discover hands-on screens-off core science curriculum for student centered K-8 classrooms. KnowAtom supports classrooms with all hands-on materials, curriculum, and professional development to support mastery of the standards.

